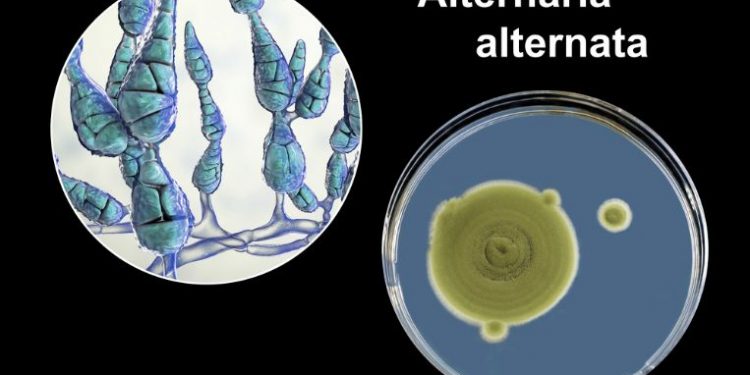

Alternaria is a common fungal genus that affects many crops. They can affect seeds, weeds, and garden vegetables. They are a serious threat to plant health, and can be severely yield limiting. They are also a major risk for mycotoxin formation. In addition, they can infect soil-borne organisms.
The most common Alternaria symptoms are brown and black spots that form on the leaves of various plants. These lesions can range from one to fifteen millimeters in diameter. They are generally distributed randomly over the leaf, but can develop concentric rings on the uppermost leaf surface. They can also have a yellow halo around the outer edge. They may cause the whole leaf to wilt. When this occurs, the infected tissue will fall off the leaf, providing entry points for bacterial infections.
Alternaria is a soil-borne fungus that can infect any Brassica plant. It can infect the foliage of potatoes, tomatoes, peppers, eggplant, radishes, and beets. It can be a problem for gardeners in warm climates, and can be a severe hazard for seedlings. However, it rarely infects virus-free sugar beet plants.
Alternaria symptoms first appear as small light-brown or black spots that develop into larger, irregularly shaped blotches. These spots are often surrounded by a dark boarder. Occasionally, the spot will become gray or tan. It will eventually merge into a larger necrotic area on the leaves.
Another Alternaria symptom is a grayish white spore mass that can develop on the underside of the leaves. The fungal spores are usually airborne, but they can also attach to the seeds and the infected plants. If the infection is severe, it can result in premature ripening of the seeds. It is important to keep your plants clean and to avoid eating the fruit or vegetables that have been affected by the fungus.
In addition to leaf spots, Alternaria symptoms can affect other parts of the plant, including the stem, root, and fruit. These symptoms often occur on older leaves, especially if they have cupped margins. They are also more likely to form on leaves that are close to the ground. If the leaf is old, it will be more susceptible to rain splash. During periods of high humidity, the spores will spread through the air. This means that it is especially important to reduce the amount of fallen leaves and weeds.
While the fungus can have a devastating impact on plants, it can be difficult to diagnose and treat. It can be difficult to determine the exact cause of the blight, but it can be attributed to nutrient deficiencies or other stresses in the growing process. In some cases, it is possible to identify the fungus, but it is more common for the symptoms to remain undetected. If you see any signs of Alternaria, you should treat the plant with a fungicide. Otherwise, the plant may not recover.
Other Alternaria symptoms include cracking through the middle of the leaf, and the appearance of a yellow or gray halo around the outer edge of the leaf. These symptoms are common on cabbage, Chinese cabbage, and other leafy crops. They are closely associated with losses of sugar yield.